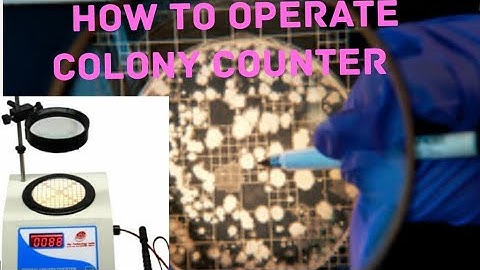
how to operate colony counter(SA.microbiology) ep-01

⬇ DOWNLOAD NOW
Kalau muncul iklan pop-up, tutup lalu klik tombol kembali
Download lagu Colony Counter Microbiological Device From A to Z secara gratis hanya untuk keperluan promosi. Dukung artis favorit kamu dengan membeli musik original di iTunes atau platform resmi lainnya.
 Laboratory Colony Counter | Clear Explain
Laboratory Colony Counter | Clear Explain
 Automated Colony Counting - BIOMIC V3 Microbiology System
Automated Colony Counting - BIOMIC V3 Microbiology System
 Microprocessor Colony Counter | Microprocessor Colony Counter Demonstration | iGene Labserve
Microprocessor Colony Counter | Microprocessor Colony Counter Demonstration | iGene Labserve
how to operate colony counter(SA.microbiology) ep-01
how to operate colony counter(SA.microbiology) ep-01
 Colony Counter Apparatus | How To Use Colony Counter | Colony Counter Instrument | ENGLISH
Colony Counter Apparatus | How To Use Colony Counter | Colony Counter Instrument | ENGLISH
 COLONY COUNTER USE IN MICROBIOLOGY LAB IN ENGLISH
COLONY COUNTER USE IN MICROBIOLOGY LAB IN ENGLISH
 Microbial Colony Counter | Microbiological tool | MLTool
Microbial Colony Counter | Microbiological tool | MLTool
 Quantica 500™
Quantica 500™